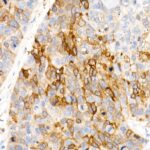

ALDH1A1 Rabbit mAb (A22351)
$148.00 – $548.00
Abclonal ALDH1A1 Rabbit mAb (Catalog Number: A22351) encoded by this gene belongs to the aldehyde dehydrogenase family. Aldehyde dehydrogenase is the next enzyme after alcohol dehydrogenase in the major pathway of alcohol metabolism.
- Product Details
- Description
- Additional information
- More Offers
| Catalog No. | A22351 |
|---|---|
| Product Name | ALDH1A1 Rabbit mAb (A22351) |
| Supplier Name | ABclonal, Inc. |
| Brand Name | Abclonal |
| Synonyms | ALDC; ALDH1; HEL-9; HEL12; PUMB1; ALDH11; RALDH1; ALDH-E1; HEL-S-53e |
| Gene Name | ALDH1A1 |
| Protein Name | ALDH1A1 |
| Uniprot/Swissprot ID | P00352 |
| Entrez GeneID | 216 |
| Clone | ARC52435 |
| Clonality | Monoclonal |
| Source/Host | Rabbit |
| Applications | WB, IHC-P, IF/ICC |
| Reactivity | Human, Mouse, Rat |
| Conjugate | Unconjugated |
| Note | Products will be shipped from the warehouse in Massachusetts. Promotion is running from time to time. Welcome to send a request for quote to message@sydlabs.com. |
| Order Offline | Syd Labs, Inc. 4 Avenue E, Hopkinton, MA 01748 USA. Phone: 1-617-401-8149 Fax: 1-617-606-5019 Email: message@sydlabs.com |
Description
A22351: ALDH1A1 Rabbit mAb
The protein encoded by this gene belongs to the aldehyde dehydrogenase family. Aldehyde dehydrogenase is the next enzyme after alcohol dehydrogenase in the major pathway of alcohol metabolism. There are two major aldehyde dehydrogenase isozymes in the liver, cytosolic and mitochondrial, which are encoded by distinct genes, and can be distinguished by their electrophoretic mobility, kinetic properties, and subcellular localization. This gene encodes the cytosolic isozyme. Studies in mice show that through its role in retinol metabolism, this gene may also be involved in the regulation of the metabolic responses to high-fat diet.
Immunogen Information about ALDH1A1 Rabbit mAb (A22351)
Immunogen:A synthetic peptide corresponding to a sequence within amino acids 250-350 of human ALDH1A1 (NP_000680.2).
Sequence:VGKLIKEAAGKSNLKRVTLELGGKSPCIVLADADLDNAVEFAHHGVFYHQGQCCIAASRIFVEESIYDEFVRRSVERAKKYILGNPLTPGVTQGPQIDKEQ
Gene ID:216
Swiss prot:P00352
Synonyms:ALDC; ALDH1; HEL-9; HEL12; PUMB1; ALDH11; RALDH1; ALDH-E1; HEL-S-53e; ALDH1A1
Calculated MW:55kDa
Observed MW:55kDa
Images of ALDH1A1 Rabbit mAb (A22351)

Western blot analysis of various lysates, using ALDH1A1 Rabbit mAb (A22351) at 1:10000 dilution.
Secondary antibody: HRP Goat Anti-Rabbit IgG (H+L) (AS014) at 1:10000 dilution.
Lysates/proteins: 25μg per lane.
Blocking buffer: 3% nonfat dry milk in TBST.
Detection: ECL Basic Kit (RM00020).
Exposure time: 30s.

Immunohistochemistry analysis of paraffin-embedded human esophageal cancer using ALDH1A1 Rabbit mAb (A22351) at dilution of 1:400 (40x lens).Perform high pressure antigen retrieval with 10 mM citrate buffer pH 6.0 before commencing with IHC staining protocol.

Immunohistochemistry analysis of paraffin-embedded human liver cancer using ALDH1A1 Rabbit mAb (A22351) at dilution of 1:400 (40x lens).Perform high pressure antigen retrieval with 10 mM citrate buffer pH 6.0 before commencing with IHC staining protocol.

Immunohistochemistry analysis of paraffin-embedded human tonsil using ALDH1A1 Rabbit mAb (A22351) at dilution of 1:400 (40x lens).Perform high pressure antigen retrieval with 10 mM citrate buffer pH 6.0 before commencing with IHC staining protocol.

Immunohistochemistry analysis of paraffin-embedded rat stomach using ALDH1A1 Rabbit mAb (A22351) at dilution of 1:400 (40x lens).Perform high pressure antigen retrieval with 10 mM citrate buffer pH 6.0 before commencing with IHC staining protocol.

Immunofluorescence analysis of A-549 cells using ALDH1A1 Rabbit mAb (A22351) at dilution of 1:100 (40x lens). Blue: DAPI for nuclear staining.
Please remember our product information: ALDH1A1 Rabbit mAb (Catalog Number: A22351) Abclonal
Additional information
| Ship from Country | USA |
|---|---|
| Size | 20 ul, 100 ul, 200 ul, 50 ul |